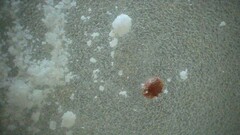
Varroa destructor

Varroa destructor: taxon details and analytics
- Domain
- Kingdom
- Animalia
- Phylum
- Arthropoda
- Class
- Arachnida
- Order
- Mesostigmata
- Family
- Varroidae
- Genus
- Varroa
- Species
- Varroa destructor
- Scientific Name
- Varroa destructor
Summary description from Wikipedia:
Varroa destructor
Varroa destructor, the Varroa mite, is an external parasitic mite that attacks and feeds on honey bees and is one of the most damaging honey bee pests in the world. A significant mite infestation leads to the death of a honey bee colony, usually in the late autumn through early spring. Without management for Varroa mite, honey bee colonies typically collapse within 2 to 3 years in temperate climates. These mites can infest Apis mellifera, the western honey bee, and Apis cerana, the Asian honey bee. Since it is very similar physically to the closely related Varroa jacobsoni, these species were thought to be one prior to 2000, but they were found to be two separate species by DNA analysis.
Parasitism of bees by mites in the genus Varroa is called varroosis. The Varroa mite can reproduce only in a honey bee colony. It attaches to the body of the bee and weakens the bee. The species is a vector for at least five debilitating bee viruses, including RNA viruses such as the deformed wing virus (DWV). The Varroa mite is the parasite with possibly the most pronounced economic impact on the beekeeping industry and is one of multiple stress factors contributing to the higher levels of bee losses around the world. Varroa mite has also been implicated as one of the multiple causes of colony collapse disorder.
Management of this pest focuses on reducing mite numbers through monitoring to avoid significant hive losses or death. 3% of bees infested in a hive is considered an economic threshold where damage is high enough to warrant additional management. Miticides are available, though some are difficult to time correctly while avoiding harm to the hive, and resistance has occurred for others. Screened bottom boards on hives can be used for both monitoring and mite removal, and drone comb, which mites prefer, can be used as a trap to remove mites from the hive. Honey bee lines in breeding programs also show partial resistance to Varroa mite through increased hygienic behavior that is being incorporated as an additional management strategy.
...Varroa destructor in languages:
- Arabic
- فاروا مدمرة
- Czech
- kleštík zhoubný
- English
- Varroa Mite
Images from inaturalist.org observations:
We recommend you sign up for this excellent, free service.